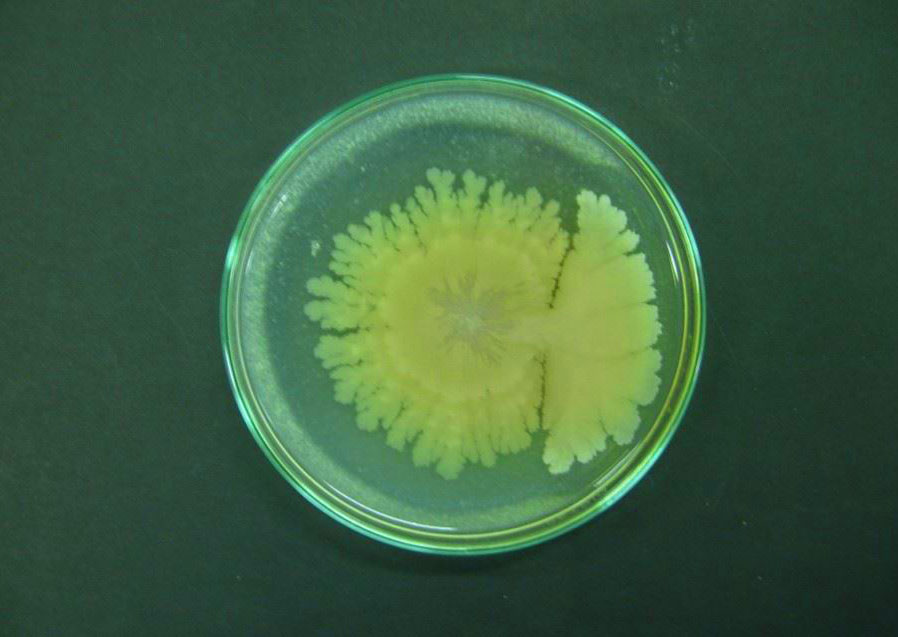

บาซิลลัส ทูริงจิเอนซิส หรือ เชื้อบีที
สร้างผลึกโปรตีน เป็นสารพิษที่ทำให้แมลงตาย

บาซิลลัส ทูริงจิเอนซิส หรือ เชื้อบีที เป็นเชื้อแบคทีเรียที่มีอยู่ทั่วไปในสภาพแวดล้อม เช่น ในดินหรือปะปนอยู่กับเศษใบไม้ มูลฝอยต่างๆ ปะปนอยู่ในเมล็ดข้าวเปลือก ข้าวสาร ฝุ่นผงตามโรงสีข้าว บนใบพืช แม้กระทั่งในบ่อน้ำ มีลักษณะรูปร่างเป็นท่อนตรง สร้างสปอร์ในเซลล์เรียกว่า endospore และสปอร์จะสร้างผลึกโปรตีน ซึ่งผลึกโปรตีนนี้ เป็นสารพิษที่ทำให้แมลงตาย
คุณสมบัติและกลไกการทำงานของเชื้อบีที:
- สร้างผลึกโปรตีน: เชื้อบีทีจะสร้างผลึกโปรตีนที่มีลักษณะเป็นแท่ง เมื่อแมลงกินเข้าไป ผลึกโปรตีนนี้จะถูกย่อยในลำไส้ของแมลง ทำให้เกิดสารพิษที่ทำลายผนังลำไส้ของแมลง
- ทำลายระบบทางเดินอาหาร: สารพิษจากเชื้อบีทีจะทำให้แมลงเป็นอัมพาตและหยุดกินอาหาร จากนั้นแมลงจะตายภายใน 1-2 วัน
- จำเพาะต่อแมลงบางชนิด: เชื้อบีทีมีความจำเพาะต่อแมลงบางชนิดเท่านั้น โดยเฉพาะหนอนผีเสื้อ หนอนใยผัก และแมลงวันบางชนิด จึงไม่เป็นอันตรายต่อแมลงที่เป็นประโยชน์ เช่น ผึ้ง และแมลงห้ำ
- ปลอดภัยต่อสิ่งแวดล้อม: เชื้อบีทีเป็นสารชีวภัณฑ์ที่สลายตัวได้ง่ายในธรรมชาติ จึงไม่ก่อให้เกิดสารพิษตกค้างในสิ่งแวดล้อมและปลอดภัยต่อผู้ใช้
ลักษณะสำคัญของเชื้อบีที
การผลิตสารพิษ: เชื้อบีทีผลิตโปรตีนคริสตัล (Cry proteins) ที่เป็นพิษต่อแมลงเมื่อถูกกระตุ้นในสภาพแวดล้อมเฉพาะ เช่น ในระบบย่อยอาหารของแมลง
ความเฉพาะเจาะจง: สารพิษจากเชื้อบีทีมีผลต่อแมลงกลุ่มเฉพาะ เช่น หนอนผีเสื้อ ( Lepidoptera ), ตัวอ่อนแมลงวัน ( Diptera ), และแมลงปีกแข็ง ( Coleoptera ) แต่ไม่เป็นอันตรายต่อมนุษย์ สัตว์เลี้ยงลูกด้วยนม และสิ่งมีชีวิตอื่นๆ ที่ไม่ใช่เป้าหมาย
การใช้ในเกษตรกรรม: เชื้อบีทีถูกนำมาใช้ในรูปแบบสารชีวภัณฑ์ เช่น สเปรย์ หรือผง เพื่อควบคุมศัตรูพืชในพืชผลทางการเกษตร เช่น ข้าวโพด ผัก และผลไม้
ชนิดของเชื้อบีที
1. Bacillus thuringiensis var. kurstaki (Btk): เป็นชนิดที่นิยมใช้กันมากที่สุด มีประสิทธิภาพในการกำจัดหนอนผีเสื้อหลายชนิด เช่น หนอนใยผัก หนอนกระทู้ผัก หนอนเจาะสมอฝ้าย นิยมใช้ในพืชผัก ผลไม้ และพืชไร่ เช่น ข้าวโพด ถั่ว ผักกาด
2. Bacillus thuringiensis var. aizawai (Bta): มีประสิทธิภาพในการกำจัดหนอนผีเสื้อบางชนิด เช่น หนอนใยผัก หนอนกระทู้หอม ใช้กับ พืชผักและพืชไร่
3. Bacillus thuringiensis var. israelensis (Bti): มีประสิทธิภาพในการกำจัดลูกน้ำยุงและลูกน้ำริ้น ตัวอ่อนยุงและแมลงวัน (Diptera)
4. Bacillus thuringiensis var. tenebrionis (Btt): มีประสิทธิภาพในการกำจัดแมลงปีกแข็งบางชนิด ด้วงปีกแข็ง (Coleoptera) ใช้ในพืชไร่และพืชผักที่ถูกทำลายโดยด้วง เช่น ด้วงหมัดผัก ที่ถูกทำลายโดยด้วง
5. Bt สายพันธุ์ที่ควบคุมไส้เดือนฝอย (Nematodes) : Bt สายพันธุ์ที่ผลิตสารพิษเฉพาะสำหรับไส้เดือนฝอย ใช้ควบคุมไส้เดือนฝอยในดินที่ทำลายรากพืช
รูปแบบผลิตภัณฑ์และการใช้งาน:
- BT มีจำหน่ายในรูปแบบต่างๆ เช่น ผงแห้ง สารละลาย และเหยื่อพิษ
เชื้อบีที มีทั้งชนิดน้ำและชนิดผง แต่ละชนิด มีอัตราการใช้ต่างกันไป ดังนี้
> บีทีสายพันธุ์ aizawai และสายพันธุ์ kurstaki มีอัตราใช้ 20 - 80 กรัมหรือซีซี/ต่อน้ำ 20 ลิตร พ่นลงบนพืชทุก 5 - 7 วัน 4 - 5 ครั้ง
> บีทีสายพันธุ์ tenebrionis ใช้ 80 - 100 ซีซี/น้ำ 20 ลิตร ฉีดพ่นหรือราดดิน 5 - 7 วันต่อครั้ง ถ้าระบาดรุนแรงใช้ 100 - 200 ซีซี/น้ำ 20 ลิตร
- การใช้งานขึ้นอยู่กับรูปแบบผลิตภัณฑ์และคำแนะนำของผู้ผลิต
- การฉีดพ่น: ผสม BT กับน้ำตามอัตราส่วนที่กำหนด แล้วฉีดพ่นให้ทั่วต้นพืช โดยเฉพาะบริเวณที่พบแมลงศัตรูพืช
- การโรย: ใช้ BT ชนิดผงโรยบริเวณที่พบแมลงศัตรูพืช หรือผสมกับดินก่อนปลูกพืช
- การใช้เหยื่อพิษ: ใช้เหยื่อพิษที่มีส่วนผสมของ BT วางไว้บริเวณที่แมลงศัตรูพืชชุกชุม
ข้อควรระวังในการใช้
- ใช้ให้ถูกช่วงเวลา: ควรใช้เมื่อพบตัวอ่อนแมลง (หนอน) เนื่องจาก Bt มีประสิทธิภาพสูงสุดเมื่อแมลงกินเข้าไป
- หลีกเลี่ยงแสงแดดจัด: แสง UV สามารถทำลายเชื้อ Bt ได้ ดังนั้นควรฉีดพ่นในช่วงเย็นหรือเช้าตรู่
- เก็บรักษาให้ถูกวิธี: เก็บผลิตภัณฑ์ Bt ในที่เย็นและแห้ง หลีกเลี่ยงแสงแดด
- ไม่ใช้กับแมลงที่มีประโยชน์: Bt มีความเฉพาะเจาะจงต่อแมลงศัตรูพืชบางชนิด แต่ควรระวังไม่ให้กระทบต่อแมลงที่มีประโยชน์ เช่น ผึ้ง
ข้อควรรู้
- แต่ละสายพันธุ์ของ Bt มีความเฉพาะเจาะจงต่อแมลงกลุ่มต่างกัน ดังนั้นการเลือกใช้สายพันธุ์ที่เหมาะสมกับแมลงศัตรูพืชจึงสำคัญ
- เชื้อบีทีไม่เป็นอันตรายต่อมนุษย์ สัตว์เลี้ยง และสิ่งมีชีวิตที่ไม่ใช่เป้าหมาย
- การใช้เชื้อบีทีควรทำตามคำแนะนำ เพื่อป้องกันการดื้อยาของแมลงศัตรูพืช
- เชื้อบีทีจึงเป็นเครื่องมือที่มีประสิทธิภาพในการควบคุมศัตรูพืชแบบปลอดภัยและเป็นมิตรต่อสิ่งแวดล้อม

บีที
เชื้อบีที
เอกสารประกอบ
การใช้บาซิลลัส ทูริงจิเอนซิส - BTs.pdf

PGS นครศรีธรรมราช
เครือข่ายเกษตรอินทรีย์ PGS นครศรีธรรมราช ขับเคลื่อนโดย สมาคมอาหารธรรมชาติยั่งยืน นครศรีธรรมราช
ที่อยู่ : ตำบลควนกลาง อำเภอพิปูน จังหวัดนครศรีธรรมราช
โทร : 0816577283
